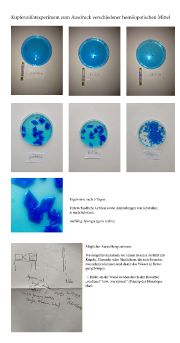

This special page shows all uploaded files.
| Date | Name | Thumbnail | Size | Description | Versions |
|---|---|---|---|---|---|
| 12:38, 6 April 2016 | Blacks3.png (file) |  |
750 KB | 1 | |
| 12:37, 6 April 2016 | Blacks2.png (file) |  |
755 KB | 1 | |
| 12:36, 6 April 2016 | Blacks1.png (file) |  |
742 KB | 1 | |
| 12:10, 6 April 2016 | Blackstruc1.png (file) |  |
6.45 MB | 1 | |
| 12:01, 6 April 2016 | Black1.png (file) |  |
1.12 MB | 1 | |
| 11:58, 6 April 2016 | Pattern1.png (file) |  |
1.08 MB | 1 | |
| 15:49, 21 February 2016 | Kupfersulfatexperiment.png (file) | |
369 KB | 1 | |
| 15:37, 21 February 2016 | Jodsalzexperiment2.png (file) |  |
541 KB | 1 | |
| 15:35, 21 February 2016 | Jodsalzexperiment.jpg (file) |  |
94 KB | 1 | |
| 15:32, 21 February 2016 | Jodsalzexperiment.pdf (file) | 1.94 MB | 1 | ||
| 21:22, 25 January 2016 | BioartWikipage.png (file) |  |
4.93 MB | 1 | |
| 10:50, 30 November 2015 | Crystal1.jpg (file) |  |
6.59 MB | Kupfersulfatkristall 1 | 1 |